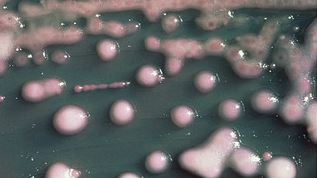
カルバペネム耐性腸内細菌（Carbapenem-resistant enterobacteriaceae、CRE）

長崎大学病院 多剤耐性菌CREに新生児15人感染 「カルバペネム耐性腸内細菌」
長崎大学病院で、抗生物質がほとんど効かない多剤耐性菌に新生児15人が感染したことがわかり、病院は、新生児の集中治療室などでの受け入れを一時停止した。
新生児2人に発熱などの症状が出たが、快方に向かっているという。
長崎大学病院は25日会見し、昨年11月から2月25日にかけて、NICU=新生児集中治療室と、NICUを出た新生児が入るGCU=回復治療室に入院中の新生児15人から「カルバペネム耐性腸内細菌(CRE)」が検出されたと発表した。
この細菌は、感染症の治療の切り札とされるカルバペネム系の抗生物質が、ほとんど効かず、アメリカで感染した入院患者が相次いで死亡したことから「CREは悪夢の細菌」とされ、厚生労働省は、全ての患者の報告を義務づけ、昨年9月から2月上旬までに、全国で106例が報告されている。
厚生労働省によると、高齢者や病気の人など免疫の働きが弱っている人が感染すると、症状が重くなるおそれがあるが、病院によると、発熱などの症状が出た新生児2人は快方に向かっているという。
病院では、施設内の滅菌などの処理を行い、感染のおそれがなくなったと確認されるまで、NICUなどでの新生児の受け入れを停止する措置をとり、必要な場合には、県内や県外の別の病院で対応できるようにするとしている。妊婦の受け入れは続けるという。
長崎大学病院の宮崎泰司副病院長は、「感染を押さえ込む方策を見つけ出来るだけ早く、受け入れを再開するようにしたい」と話している。
以上、
大丈夫かなぁ?アメリカでは大問題になっているが・・・
カルバペネム耐性腸内細菌(Carbapenem-resistant enterobacteriaceae、CRE)は、薬剤耐性菌の一種
CREは、カルバペネマーゼ(β-ラクタム系抗生物質を加水分解する酵素のこと)を産生する、そのため、抗菌薬であるカルバペネム系抗生物質(イミペネムやメロペネムなど。悪性感染症の治療の最終手段として使われることが多い。)が効かなくなる。
腸内細菌科の細菌の一種であり、他の腸内病原体にも抗生物質耐性を与えてしまうこともあるという。
人間の消化器官に棲息しやすい特性を持ち、常在していることもある。
発症と感染予防
CREが、膀胱や血液などに到達した場合、感染症を引き起こす可能性があるという。血流感染が起きると、最大で患者の50%が命を落とすといわれている。
国内の医療機関(病院など)において感染が確認されているアメリカ合衆国では、疾病予防管理センター(CDC)が院内感染防止策として、「手洗いの励行」「カテーテルや人工呼吸器など医療器具の取扱いの注意」「感染患者の隔離」などを呼びかけている。
米疾病対策予防センター(CDC)は2013年3月5日、カルバペネム系と呼ばれる強力な抗生物質(悪性感染症の治療の最終手段として使われることが多い)に、耐性を持つ腸内細菌への感染の比率は、2011年時点で4.2%と10年前の1.2%から増えている。
それらの腸内細菌の中で最も厄介な部類とされるクレブシエラ(グラム陰性の桿菌)では、さらに顕著で、薬剤に耐性を持つ細菌の比率が10.4%と、10年前の1.6%を大きく上回っている。
これらはカルバペネム耐性腸内細菌(CRE)と呼ばれる。これによる血流感染が起きると、約半数もの患者が命を落とす。
CDCのトム・フリーデン所長は記者会見で、「CREは悪夢の細菌だ」と述べ、「われわれの持つ最も強力な抗生物質が効かないため、感染した患者にはなすすべがないと言っていい」と付け加えた。
以上、
アメリカは、CREに対しては、日本より慎重に対応しているようだ。
2014年03月31日の日本の記事「CRE西日本で拡大中」
国立病院機構大阪医療センターで少なくとも患者2人が死亡
2010年7月からの約3年半に入院した114人の患者が保菌・感染していた。この耐性菌による大規模院内感染の報告は国内では初めてという。
新型耐性菌「CRE」が原因
大規模な院内感染の原因になった新型耐性菌「CRE」は、通常の検査では検出困難な「ステルス型」と呼ばれる種類だと分かった。
日本で初報告された新型耐性菌「CRE」
5年前に広島県で初めて見つかった新しい型で、治療が手遅れになりやすい特性がある。
複数の専門家が「日本で生まれたと見られるCREが、西日本に広がりつつある」と警告する。
広島大の鹿山鎮男助教らは、2009年に初めて広島県内の複数の病院からステルス型CREを5株見つけ、その後、兵庫県の病院からも8株見つけた。
検出数は年々増え、12年10月までに2県で計87株にのぼる。
その間にこの菌による死者が少なくとも1人出た。
鹿山助教らが詳しく調べると、ほぼ全ての菌で、リング状の細胞内物質「プラスミド」が同一だった。
抗菌薬が効かない!
一般的なCREは、切り札的な抗菌薬であるカルバペネムが効かない。
それに加え、ステルス型は実際にはカルバペネムが効かないのに、通常の検査法では「効く」という誤った結果が出る特異性がある。
このため、検出しにくいだけでなく、医師が検査結果を信じてカルバペネムを治療に使い、手遅れになる恐れも強い。
「殺人菌を食い止めろ!」
米疾病対策センター(CDC)は今春、米国で急速に広がる新型多剤耐性菌「CRE」への注意を呼びかけています。
ただ、米国の医療機関でCREはまだそれほど頻繁に見つかっているわけではなく、健康な人の間で感染が広がっている様子も見られないそうです。
米国では年間約170万人が院内感染し、9万9000人が死亡しています。
CREに血流感染した患者の致死率は最大で50%に達しているそうです。
以上、
CREは、治療法が未知の領域の細菌であり、病院は充分すぎるほど慎重に対応してもらいたいものだ。
院内感染?
CDC/HICPAC急性期病院におけるカルバペネム耐性腸内細菌(CRE)制御のためのガイダンス
http://www.cdc.gov/mmwr/preview/mmwrhtml/mm5810a4.htm
追、最新<内視鏡で感染か?179人>
2月24日ロイターの報道では、
ロナルド・レーガンUCLA医療センターで2月18日、センター内でカルバペネム耐性腸内細菌(CRE)「スーパーバグ」に感染したことが発覚、7人中2人が死亡。5人は治療を受けている。ほかに、内視鏡を使った治療を通じて179人の患者が感染した疑いが持たれている。





コメントをどうぞ